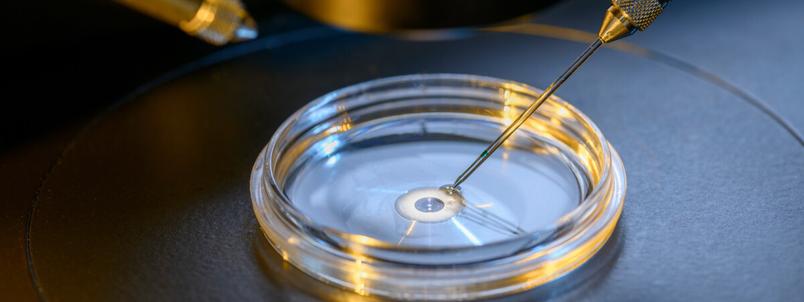
ivf-petri-dish

Understanding Hyperovulation & What It Means for Your Fertility


So, you know how women release that one egg a month during ovulation? 🥚
Well, that’s not always the case…
“Say, whattttt?!”
Sometimes, you can release multiple eggs, known as hyperovulation, which can then lead to fraternal multiple births. 👶👶
So, how can you tell if you’re hyperovulating?
How rare is it, and does it have any symptoms? 🤔
We’re here to give you the lowdown on hyperovulation, and what it means for you.
In this article: 📝
•
What is hyperovulation?
•
How rare is hyperovulation?
•
How do you know if you have hyperovulation?
What is hyperovulation?
Also known as ‘super-ovulation’, hyperovulation is when a woman releases more than one egg during her menstrual cycle.
And, if these eggs are fertilized, this is responsible for creating multiple births (more on this later! 👇).
It’s not easy to tell if you’ve hyperovulated, as the symptoms don’t usually present any differently to your usual ovulation symptoms.
But, if you are prone to hyperovulation, it might actually improve your chances of conception, as there are more opportunities to conceive.
🔍 Read More: Can You Ovulate Twice in a Month?
What causes you to hyperovulate?
Well, in many cases, it sort of just… happens (more on how common this is later 👇).
But, a direct cause of hyperovulation could be due to:
- 🤰 Fertility treatments: These are often used to encourage pregnancy, for example, like IVF (which involves stimulating the ovaries to produce multiple eggs).
- 📈 Hormonal imbalances: This can happen from hormonal birth control, especially when you stop using it, as your body may experience a number of unexpected symptoms while readjusting to the new hormone levels. It could also be caused by hormonal disorders, such as PCOS. [1] [2]
And, some say that there may be certain factors that could make hyperovulation that bit more likely:
- 🧬 Genetics: There are theories that ‘twins run in the family’ so, on that basis, surely hyperovulation should, too? [3]
- 👩 Age: As we near the end of our childbearing years, we're more likely to hyperovulate. This is because the number of eggs we have has started to decline. Our bodies respond to this by increasing our FSH production, which is a hormone that stimulates our egg production. When we have a higher FSH level, this increases our chances of hyperovulation — i.e., becoming pregnant with twins! [4]
But, generally, you don’t even know you’ve hyperovulated until much later down the line, when healthcare professionals diagnose it after you’ve developed multiple pregnancies at once. 👶

So, does hyperovulation cause twins?
Not always, but it certainly can — yes!
But, importantly, it causes fraternal twins, rather than identical. 👬
👶👶 Quick recap: fraternal twins are created from two eggs which are fertilized by two sperm, producing two genetically unique children. Identical twins are produced from just one egg which splits, and develops into two babies with the exact same DNA. 🧬 [5]
So, hyperovulation — the process of releasing more than one egg that month — can only cause fraternal twins, also known as dizygotic twins.
But, in many cases, hyperovulation occurs and these eggs aren’t fertilized, or maybe only one is fertilized.
So, just because you’ve hyperovulated, this doesn’t necessarily mean you will have twins, or that you’ll even be pregnant at all.
It’s alllll about the timing. 😌
🔍 Get Clued Up: How to Conceive Twins
But, doesn’t that mean hyperovulation could also cause triplets, and quadruplets, too?
You got it — triplets, quadruplets, and the rest(!) are on the cards, too. ✅
Essentially, hyperovulation can allow for multiple eggs to be released during ovulation, which can then be fertilized by multiple sperm… making multiple fetuses.
And multiple babies. 👶👶👶
How rare is hyperovulation?
Well, experts are saying it’s more common than they initially thought. 🤯
One study says that “the conventional belief that women ovulate once a month is wrong”. 🤔 [6]
The study goes on to show that women can potentially ovulate two, or even three, times a month, and 40% of their 63 participants had the potential to produce more than one egg a month.
Another study suggests that in women over the age of 35 years, there's an increase in their capability to hyperovulate. [7]
So, now, it’s considered a bit more common…
But whether or not your egg gets fertilized during hyperovulation, or you have multiple fertilizations, is another story.
How can you trigger hyperovulation?
As mere mortals, we have little control over hyperovulation as a naturally occurring process.
Stopping taking hormonal medication, like birth control, might cause some initial hormonal imbalances, but it’s definitely not a set way to trigger hyperovulation (and it comes with other side effects, too).
But medically induced hyperovulation is a bit of a different story. 👩🔬
This is often conducted as part of fertility treatments, which aim to improve the odds of pregnancy. 🤰
IVF, for example, could use medications that can induce hyperovulation, as the aim of the game is to give you the best chance at conception as possible. [8]
How do you know if you have hyperovulation?
So, what does hypovulation actually feel like? 🤔
Well, hyperovulation doesn’t usually have any symptoms that are massively different from usual ovulation.
So, it can be kinda tricky to tell if you’re hyperovulating!
(It comes as more of a surprise a couple of months down the line to learn you’re carrying multiple births 😅).
But, ovulation itself has a bunch of symptoms you can keep an eye out for:
- 🤍 Cervical mucus: Changes in your discharge are common when you’re ovulating — going from dry cervical mucus as the start of your cycle, to more “egg-white”, stretchy discharge when you’re ovulating.
- 😮💨 Cramping: Ovulation can cause us a few pangs of pain here and there. For some, it can be more intense than others. So, be sure to take care of yourself during this time if you need to. ❤️
- 🤢 Nausea: You might also feel some ovulation nausea, too. Your hormones are flying all over the place during ovulation, so this can cause a bit of an unsettled stomach sometimes.
- 😈 Arousal: Did you know, ovulation can actually make you more turned on, too? It’s Mother Nature’s way of coaxing your body into fertilizing that egg… clever, right?
- 🌡️ Basal body temperature: You can also check if you’re ovulating by tracking your basal body temperature. During ovulation, your body temperature rises slightly, so it’s a good indicator that ovulation is taking place. 🥚

Does hyperovulation cause heavy periods?
There’s no direct evidence that hyperovulation can cause heavy periods.
But, women who have polycystic ovary syndrome (PCOS), or other hormonal disorders, could ovulate more than once in their cycle due to their irregular hormone levels. [9]
Stephanie says she's "experienced multiple LH surges in her cycle", and she also suffers from PCOS. 🥜
This could be because the treatment for PCOS is a medication that causes ovulation to happen, so it’s then thought this might increase the chance of multiple births. [10]
But, a common symptom for women with PCOS is long menstrual cycles, and heavy periods. 🩸[11]
So, the hyperovulation itself likely wouldn’t cause heavy periods, if you are experiencing hyperovulation because of a hormonal condition, that may also come hand-in-hand with heavy periods.
Got some questions about hyperovulating we haven’t answered?Or perhaps you’ve hyperovulated before and want to chat to women who’ve also been through it?
Join us on Peanut. 🥜
Want to find your village?
Scan to Join
Rated 4.4
Trusted by 5M+ women
.png?_wwcv=1371)



















